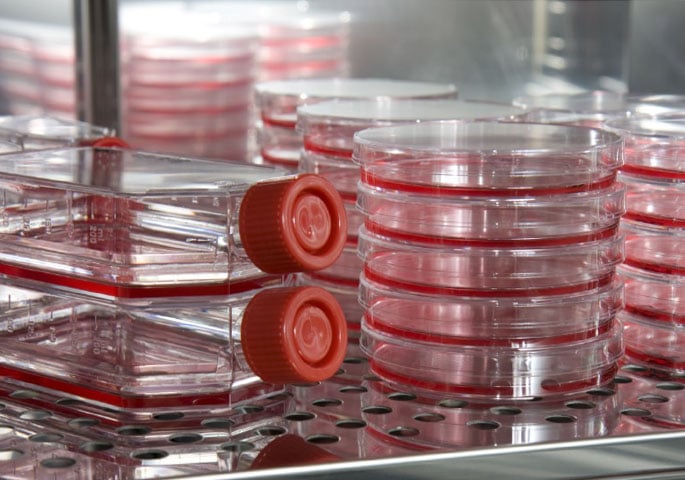

Étude de cas Université de l'État de Pennsylvanie

Exigences
-
Conditions de croissance reproductibles
-
Risque de contamination réduit
-
Croissance optimale de cultures cellulaires
-
Grande sécurité des processus
Solutions BINDER
-
Concept de décontamination fiable
-
Grande homogénéité de température
-
grâce au système d’enveloppe à circulation d’air VENTAIR™
-
Humidité relative de l’air élevée
-
jusqu’à 95 % HR
-
Valeurs de pH stables grâce à une sonde
-
infrarouge CO2/O2 sans dérive

L’institut des sciences du vivant de l’université d’État de Pennsylvanie s’est spécialisé dans l’étude des cellules souches embryonnaires.
L’étude des cellules souches joue un grand rôle dans la lutte contre de nombreuses maladies, en ce qui concerne le traitement contre le cancer par exemple. Elle ouvre de toutes nouvelles perspectives, en particulier dans le domaine de la médecine régénérative. Grâce à la thérapie par les cellules souches ou la transplantation de cellules souches, des cellules et organes qui ne fonctionnent plus peuvent être rétablis ou remplacés à l’aide de tissus cultivés in vitro.
L’institut des sciences du vivant de la très réputée université d’État de Pennsylvanie s’est spécialisé dans l’étude des cellules souches embryonnaires (CSE). Les travaux de recherche concernent de multiples applications dans le domaine de la recherche biomédicale fondamentale ainsi que de la recherche scientifique axée sur les applications.
Le terme CSE désigne les cellules souches issues des premiers stades embryonnaires. En raison de leur capacité de prolifération et de leur potentiel de différenciation illimités, elles constituent une source variée et quasi infinie de remplacement des cellules et des tissus. Dans le domaine de la recherche fondamentale, il s’agit d’examiner le développement et la régulation des premiers stades des cellules souches et d’étudier les processus sur lesquels repose la capacité des cellules souches à proliférer et à se différencier. Dans la recherche clinique, l’utilisation des CSE offre la possibilité de traiter avec succès différentes maladies, comme les maladies cardiovasculaires ou neurodégénératives.
Rossi apprécie aussi particulièrement le système de mesure du CO2 sans dérive avec sonde infrarouge. La buse de mélange de gaz conforme au principe Venturi garantit une répartition homogène du CO2, ce qui permet de stabiliser de manière permanente la valeur de pH du milieu. Cela assure une croissance cellulaire optimale.
« Je travaille depuis 15 ans environ avec les étuves bactériologiques de BINDER et je suis entièrement satisfait du fonctionnement ainsi que des prestations d’entretien. Elles sont fiables à 100 % et disposent, grâce aux conditions de température et d’humidité constantes, des meilleures propriétés d’incubation possibles », conclut le scientifique.
Avantages
- Conception de chambre brevetée pour une sécurité maximale des échantillons
- Stérilisation à air chaud à 180 °C
- Capteur de CO2 stérilisable
- Technologies BINDER uniques (système d'enveloppe à circulation d'air breveté, contrôle de la condensation, etc.)
Domaine d'application
- Biotechnologies
- Ingénierie Bio Tissulaire
- Cliniques/Cliniques universitaires
- Fécondation in vitro
